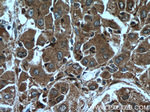
PFDN2 Antibody in Immunohistochemistry (Paraffin) (IHC (P))

Search
Proteintech
PFDN2 Polyclonal Antibody
{{$productOrderCtrl.translations['antibody.pdp.commerceCard.promotion.promotions']}}
{{$productOrderCtrl.translations['antibody.pdp.commerceCard.promotion.viewpromo']}}
{{$productOrderCtrl.translations['antibody.pdp.commerceCard.promotion.promocode']}}: {{promo.promoCode}} {{promo.promoTitle}} {{promo.promoDescription}}. {{$productOrderCtrl.translations['antibody.pdp.commerceCard.promotion.learnmore']}}
产品信息
13053-1-AP
种属反应
宿主/亚型
分类
类型
抗原
偶联物
形式
浓度
规格
纯化类型
保存液
内含物
保存条件
运输条件
产品详细信息
Immunogen sequence: MAENSGRAG KSSGSGAGKG AVSAEQVIAG FNRLRQEQRG LASKAAELEM ELNEHSLVID TLKEVDETRK CYRMVGGVLV ERTVKEVLPA LENNKEQIQK IIETLTQQLQ AKGKELNEFR EKHNIRLMGE DEKPAAKENS EGAGAKASSA GVLVS (1-154 aa encoded by BC012464)
靶标信息
Binds specifically to cytosolic chaperonin (c-CPN) and transfers target proteins to it. Binds to nascent polypeptide chain and promotes folding in an environment in which there are many competing pathways for nonnative proteins.
仅用于科研。不用于诊断过程。未经明确授权不得转售。
篇参考文献 (0)
生物信息学
蛋白别名: prefoldin 2; Prefoldin subunit 2; unnamed protein product
基因别名: ESTM27; HSPC231; PFD2; PFDN2; W48336
UniProt ID: (Human) Q9UHV9, (Mouse) O70591
Entrez Gene ID: (Human) 5202, (Mouse) 18637